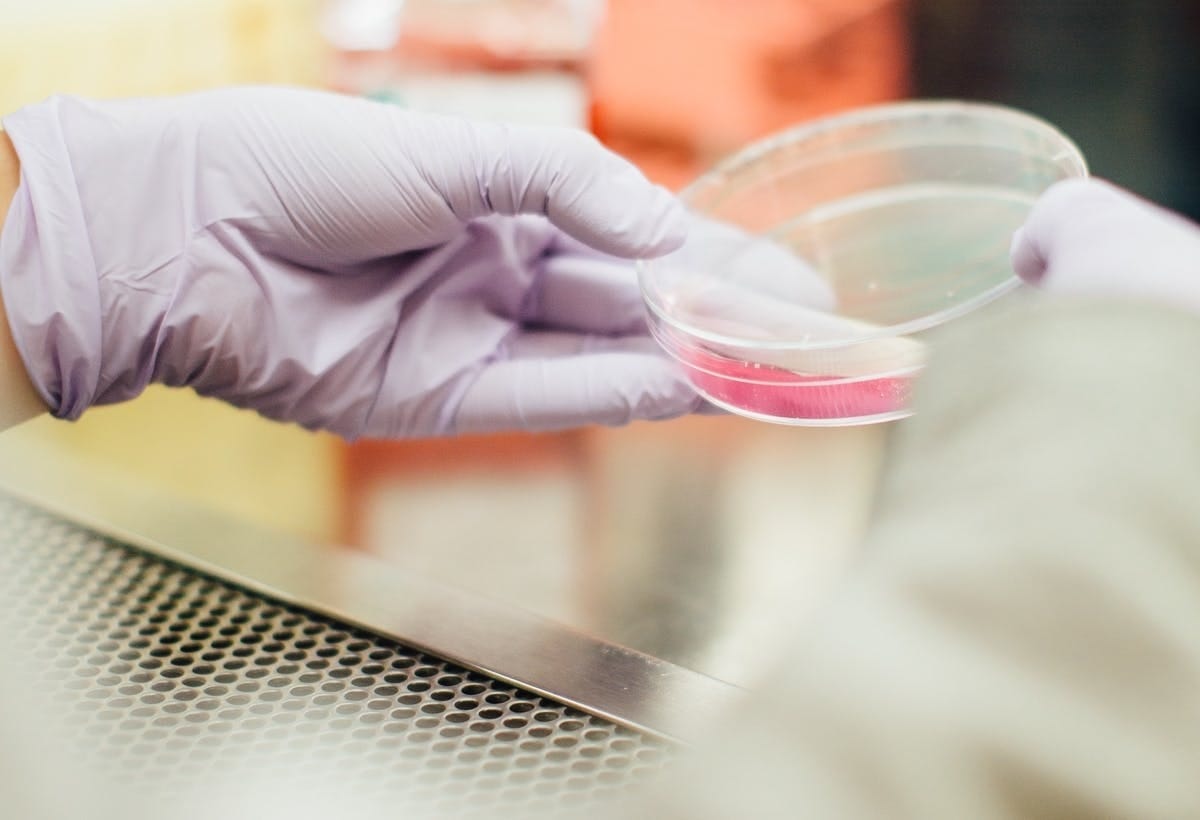

Friday 12th November 2021

Let’s Talk: How to provide a safe post-pandemic workplace for employees and customers
Keeping employees and customers safe took on new meaning when COVID-19 reshaped how businesses operate. Not only do we now need to provide a physically safe space, but one in which people feel emotionally secure and supported.Our experts weigh in on the technology, management styles and protocols needed to adapt.Let’s Talk…

Innovative incubator initiative offers Melbourne’s foodpreneurs to make a comeback
An initiative led by Melbourne Innovation Centre is giving training, professional development, and industry experience to early-stage food start-ups and founders to help them expand.

Morrison’s $1billion green tech fund
The Federal Government has announced the creation of a new $1 billion fund to invest in green technology. As part of the new Low Emissions Technology Commercialisation Fund, Prime Minister Scott Morrison’s Government has committed $500 million, with the other half expected to be matched by private investment.
Victorian Angel Group to invest up to $2m in healthtech startups after LaunchVic funding
Australian Medical Angels — a clinician-focused angel network — will launch a dedicated Victorian branch and invest up to $2 million in ten early-stage healthtech startups from Victoria after receiving funding from the state government’s startup agency, LaunchVic, to support its thriving life science startup community.

Performance Management vs Disciplinary Action: The Differences Explained
Many employers find performance management, or instigating disciplinary action against employees for misconduct, difficult and emotionally challenging. It can be hard for an employer to distinguish between misconduct and underperformance; it’s harder still managing an employee through either a disciplinary or a performance management process with confidence.

Grub Lab kicks off augmented reality photo opportunity with Santa for Christmas during COVID-19
Grub Lab, an innovative hospitality tech company, is offering Augmented Reality (AR) Santa photos this Christmas called ‘Santagram.’ The AR photos will allow 100,000 families attending hospitality venues in the lead up to Christmas to capture pictures with Santa despite the restrictions imposed due to COVID-19.

Bon a-pet-treat: This pet tech startup is delivering curated meals at the doorstep for dogs
A Melbourne-based startup wants to serve your dog curated meals based on real-time data. ilume is the first pet health ecosystem to deliver chef-prepared meals for dogs to the customer’s door.

Four ways I used Instagram to help save my retail business
The arrival of COVID-19 brought with it many challenges for my retail fashion business. Before our first lockdown in early 2020, Carolina Lifestyle was very much a traditional bricks-and-mortar model, with 80 per cent of my sales coming through my stores across the Sydney and Melbourne area. Business was booming, and as a result, our online store was not our focus. Then along came COVID-19, and it was as though someone had turned off the tap. Our stores were instantly closed, and with everybody stuck at home with nowhere to go, we were lucky if we were getting a handful of online sales each week.

U.S. experiences post-pandemic inflation: Will Australia follow?
U.S. inflation has hit a three-decade high in October, with consumer prices rising by 0.9 per cent. Inflation has been fuelled by a consumer price surge in food products, petrol and a sluggish global supply chain. The U.S. Consumer Price Index rose by 6.2 per cent in October year on year, the most significant jump since 1990.

Australia Post urges retailers to manage customer expectations amid holiday shopping surge
Australia Post has warned of further delivery delays as the postal service, already overburdened by recent shopping spikes, is now being hit by a surge of online sales events and pre-Christmas shopping.



